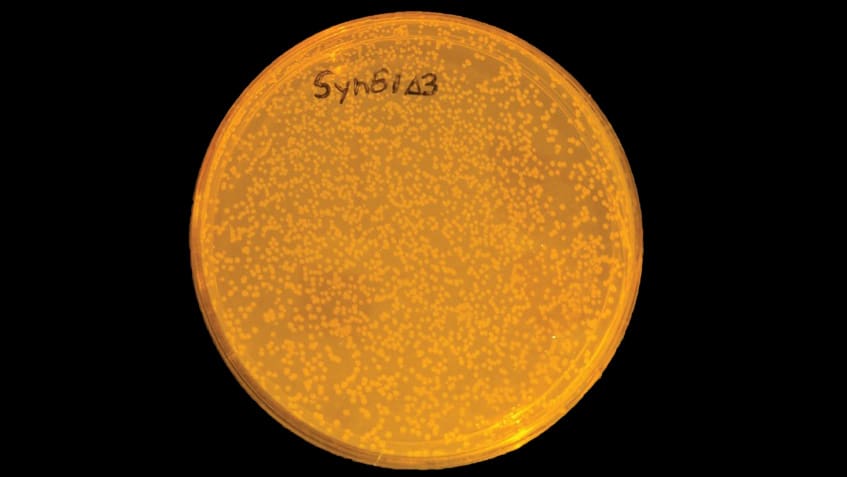
The reprogrammed bacteria Syn61 growing on a plate

Cells created with a synthetic genome are instructed to make polymers from artificial building blocks for the first time; the new bacteria are also resistant to viral infections
All known life uses 64 codons to encode for the 20 common amino acids and stop signals which are used to build proteins. Previously, Jason Chin’s group, in the PNAC Division, designed and synthesised an entire E. coli genome in which three codons were removed. The new genome uses just 61 codons, but synthesizes all the normal proteins, and the cells containing the synthetic genome thrive. This work provided the first example of a living organism with a compressed genetic code and the genome of Syn61 is still the largest, and most radically altered, functional genome ever constructed.
Now Jason’s group has further engineered this synthetic E. coli strain, known as Syn61. The new strains enable the efficient introduction of three distinct non-canonical amino acids into proteins, the first genetically encoded cellular synthesis of completely synthetic polymers, and are completely resistant to viruses.
Each codon tells the cell to add a specific amino acid to the chain – it does this via molecules called ‘tRNA’. Each codon has a specific tRNA that recognises it and adds the corresponding amino acid to a growing protein chain, for example: the tRNA that recognises the codon ‘TCG’, brings the amino acid serine. Jason’s group demonstrated that removing the three codons from the genome of Syn61 enabled the two tRNAs and one release factor (a protein that acts in place of tRNAs to recognize a codon that normally signals termination of protein synthesis) that normally recognise these codons to be deleted. This created a cell, Syn61Δ3, which cannot read the canonical genetic code. The team hypothesized that this cell would be resistant to viruses, as it would be unable to read viral genomes that use the full genetic code. Julius Fredens, a postdoc in the group, infected bacteria with a cocktail of viruses. Unmodified normal bacteria were killed by the viruses, but the modified bacteria were resistant to infection and survived; this demonstrated that Syn61Δ3 was resistant to infection with diverse viruses.
Making bacteria resistant to viruses could make manufacturing certain types of drugs more reliable and cheaper. Many drugs – for example, protein drugs, such as insulin, and polysaccharide and protein subunit vaccines – are manufactured by growing bacteria which contain instructions to produce the drug. If a virus gets into the vats of bacteria used to manufacture certain drugs then it can destroy the whole batch. The modified bacterial cells could overcome this problem by being completely resistant to viruses.
The group also demonstrated that they could turn cells into living factories for encoded polymer synthesis. By creating bacteria with synthetic genomes that do not use certain codons, the researchers had freed up those codons to be available to be used for other purposes, such as coding for synthetic building blocks, called monomers. Postdocs Wesley Robertson and Daniel de la Torre – building on work discovering new tRNAs and aminoacyl-tRNA synthetase enzymes, by former PhD student Daniele Cervettini and current PhD student Daniel Dunkelmann – engineered the bacteria to produce tRNAs coupled with artificial monomers, which recognised the newly available codons. This allowed them – working with Thomas Elliott, a senior scientist in the group – to produce new recombinant proteins containing one, two, or three distinct non-canonical amino acids. This work took advantage of evolved versions of Syn61 – developed by Louise Funke, a PhD student in the group – which grow more similarly to laboratory E. coli strains.
Wesley and Daniel then inserted genetic sequences with strings of the available codons into the bacteria’s DNA. These were read by the altered tRNAs, which assembled chains of synthetic monomers in the sequence defined by the sequence of codons in the DNA. The cells were programmed to string together monomers in different orders by changing the order of the available codons in the genetic sequence. Polymers composed of different monomers were also made by changing which monomers were coupled to the tRNAs.
The group created polymers made of up to eight monomers strung together, and encoded the synthesis of twenty-two distinct new polymer sequences. Postdoc Martin Spinck, working closely with Wesley and Daniel demonstrated that the head and tail of the new polymers could be linked to make cyclic polymers known as macrocycles, a class of molecules that forms the basis of numerous drugs, including antibiotics.
This work was funded by UKRI MRC and the European Research Council.
Further References
Sense codon reassignment enables viral resistance and encoded polymer synthesis. Robertson, WE., Funke, LFH., de la Torre, D., Fredens, J., Elliot, TS., Spinck, M., Christova, Y., Cervettini, D., Böge, FL., Liu, KC., Buse, S., Maslen, S., Salmond, GPC., Chin, JW. Science, Vol. 372, Issue 6546, pp. 1057‑1062
Science Perspective: Rewriting the genetic code
Science News Story: New approach to rewriting bacteria’s genetic code could lead to novel medicines
Previous Insights on Research
Creating an entire bacterial genome with a compressed genetic code
Making a cell-based factory for polymer synthesis
New technologies enable systematic recoding of genomes


